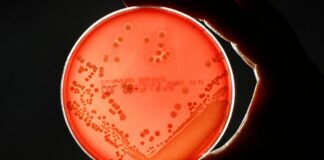
Les infections bactériennes, deuxième cause de décès dans le monde

L’Echo d’Algérie, Quotidien National d’Information édité par Echo Médias Algérie Sarl, venu enrichir la presse écrite, jeune par son âge certes mais en réalité c’est le prolongement d’un idéal, d’un combat, d’un rêve.
L'Echo d'Algérie © 2014-2024 Tous droits réservés